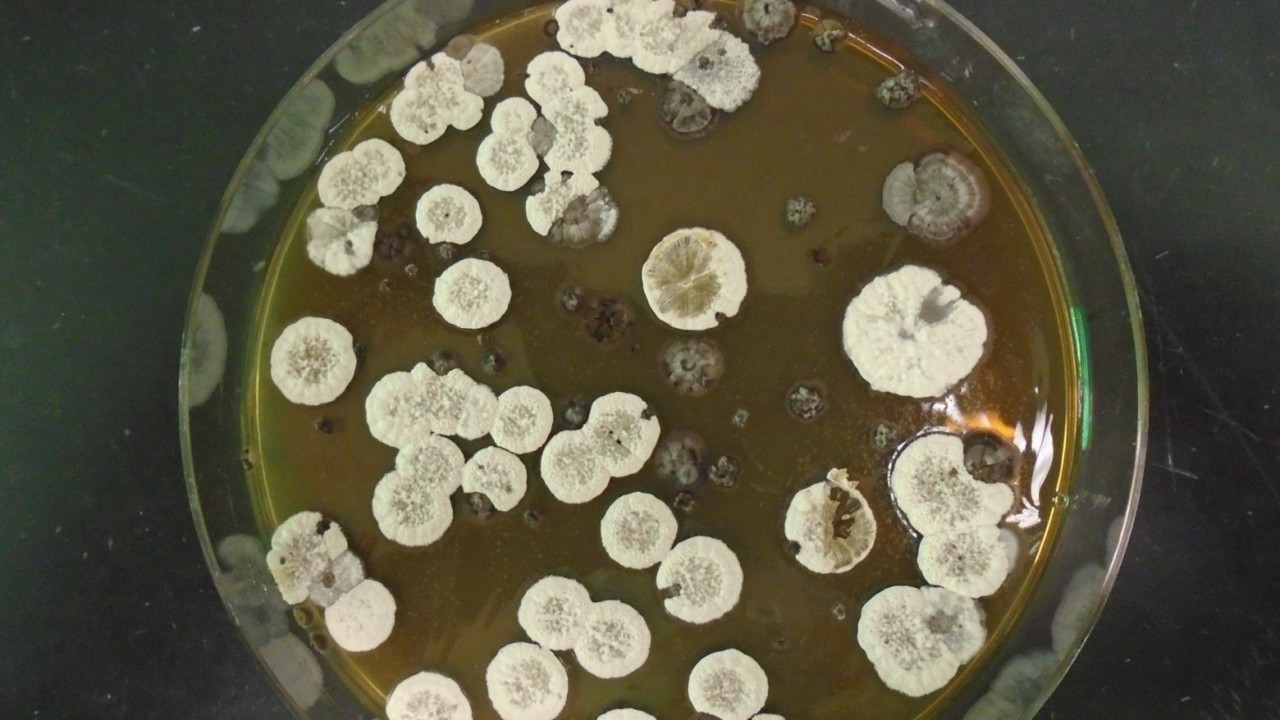

Space News & Blog Articles
Tune into the SpaceZE News Network to stay updated on industry news from around the world.
Bacteria could make super-efficient rocket fuel
It's an early-stage project, but researchers say a new biofuel holds potential for low-carbon rocket launches.
Stay Informed
When you subscribe to the SpaceZE News Feed, we will send you an e-mail when there are new updates on the site so you wouldn't miss them.